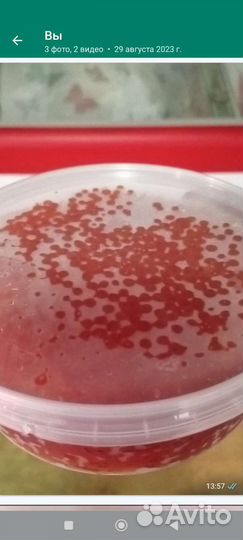
Красная икра 2023

Красная икра 2023
2 900 руб.
Икра 2023.Качество премиум(Камчатка)!!! Минимальный заказ 500гр.2900 руб
(Звоните пожалуйста по существу!!!)
Объвление найдено на сайте avito.ru. Перейдите по ссылке для покупки или просмотра более подробной информации